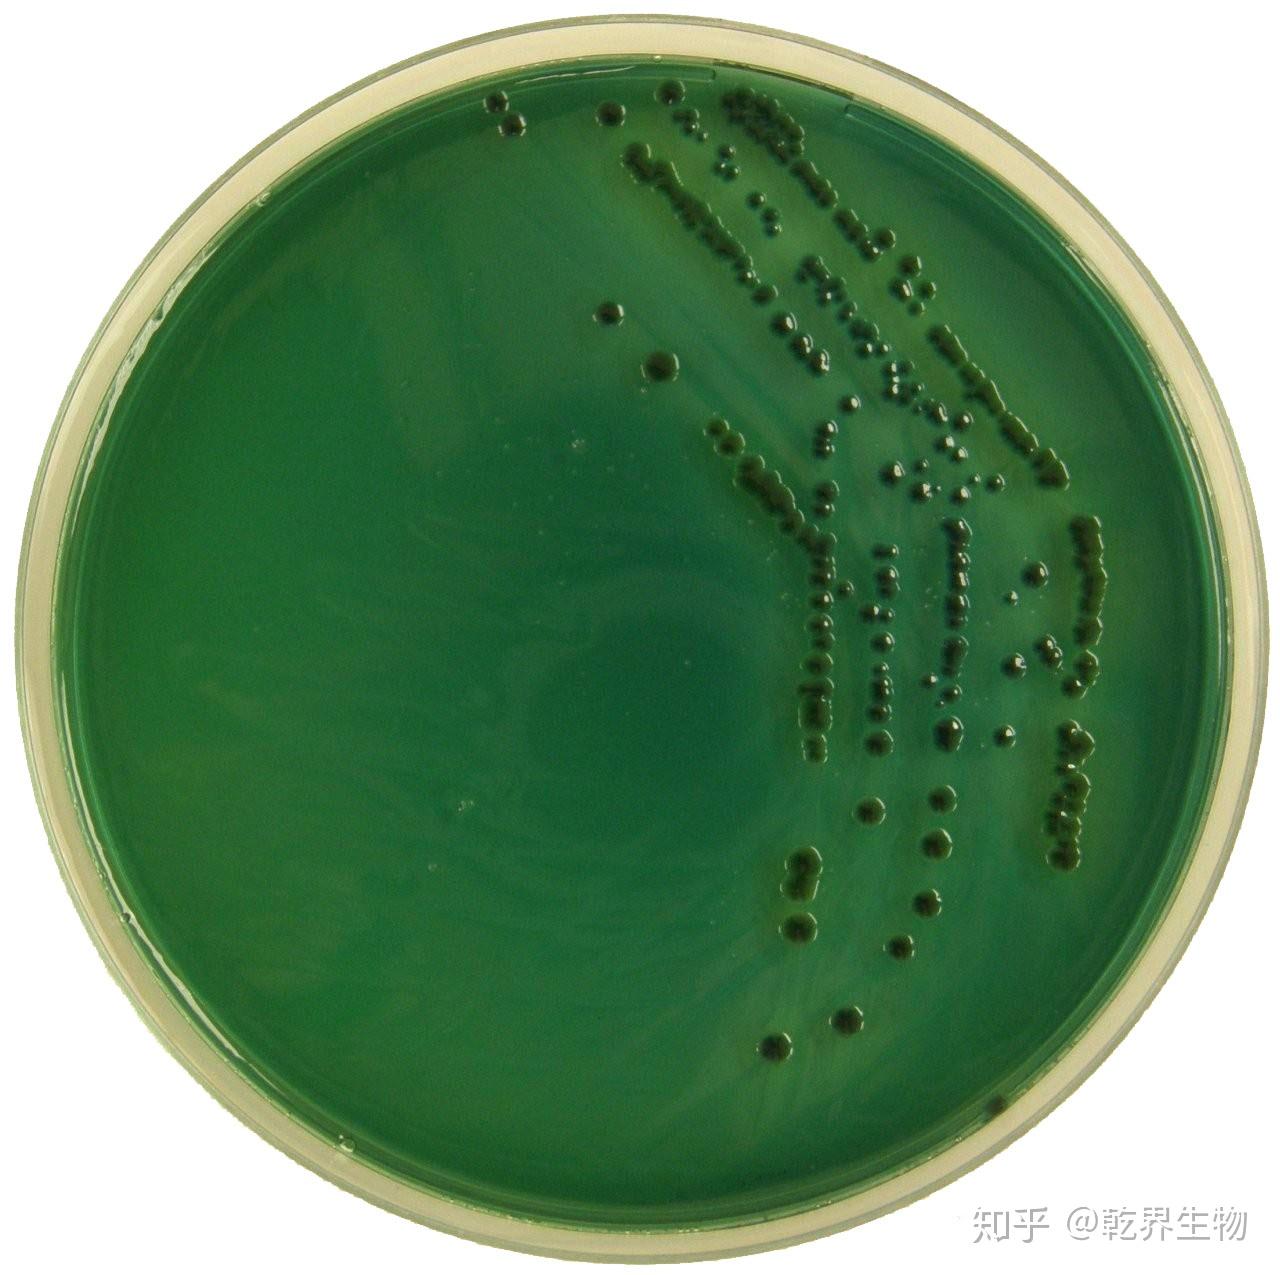
绿弧菌对虾的影响
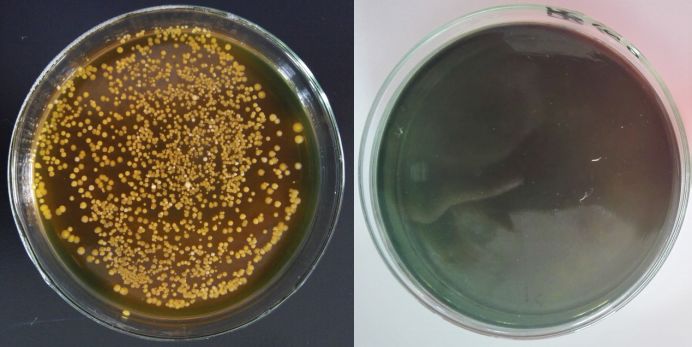
88底舒宝对哈维氏弧菌的抑制效果缓释增氧,高效持久88通过吹气球
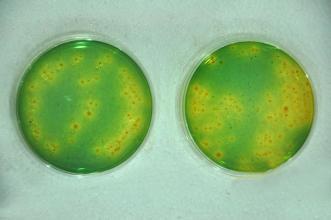
资深养殖户不传之秘教你一招搞定弧菌病
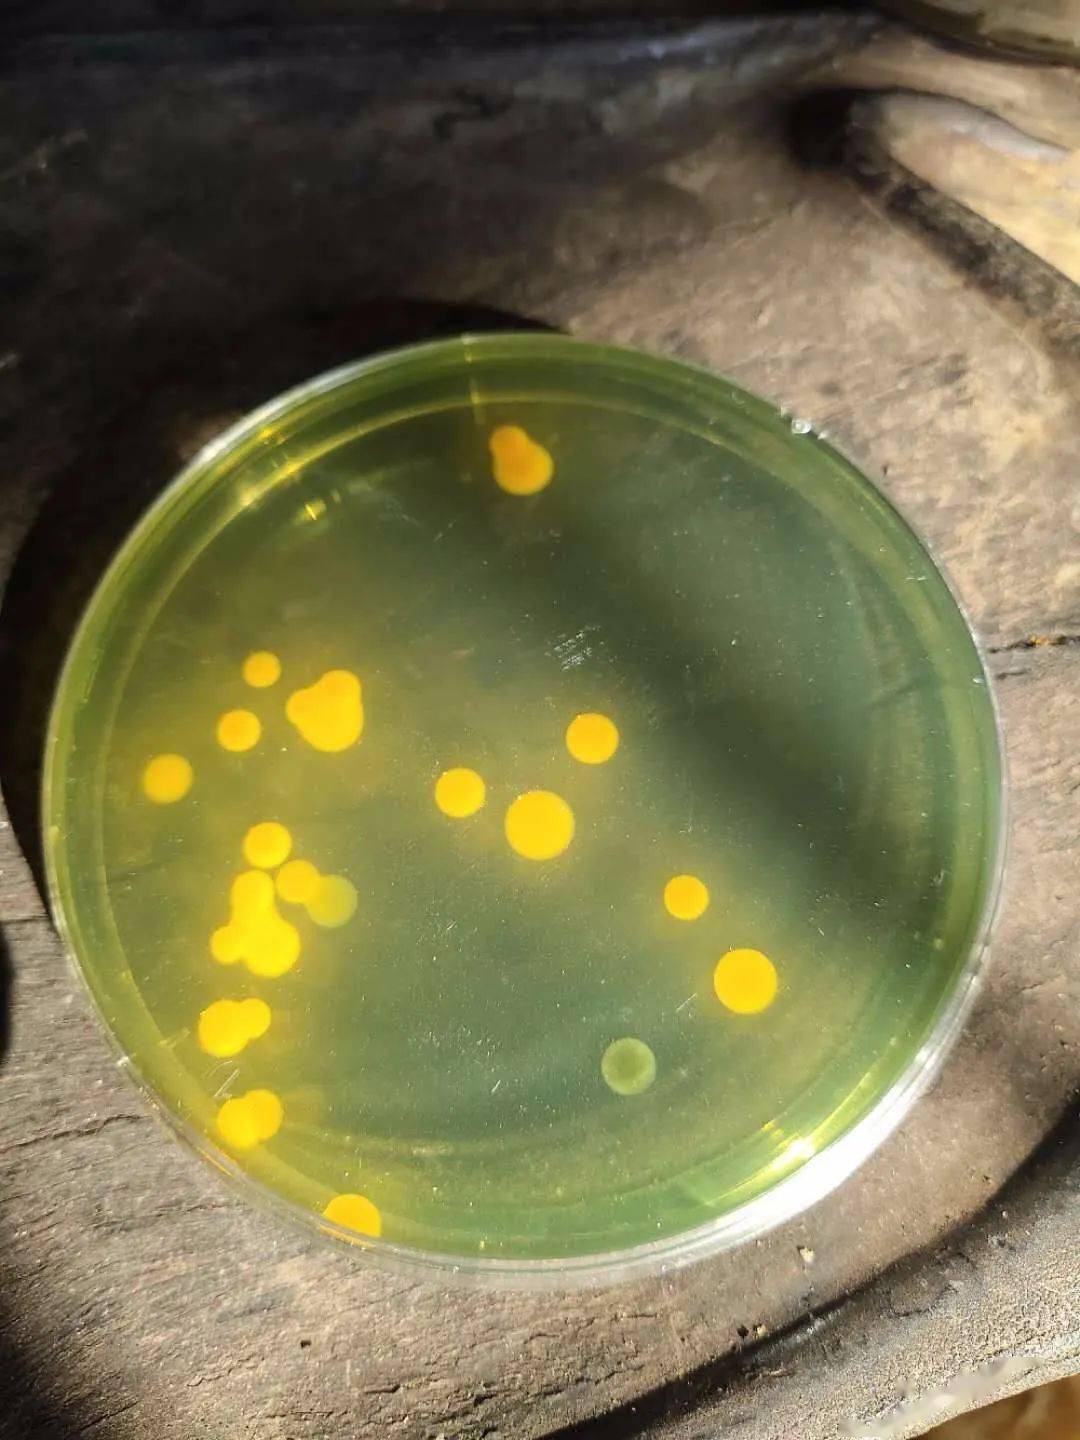
夏天高温肠炎白便爆发把弧菌赶尽杀绝才安心

哈维氏弧菌

哈维氏弧菌感染的症状,死虾在夜间会发光,值得注意的是这种发光不是在
图片尺寸435x240
史上最全弧菌预防方案小龙虾养殖户必读
图片尺寸1080x1920
弧菌
图片尺寸756x504
哈维氏弧菌按照方法活化活化不成功
图片尺寸1080x1440
微生物显微图
图片尺寸500x400
(医学微生物学)12 弧菌教程文件.ppt
图片尺寸1296x864
绿弧菌对虾的影响
图片尺寸1280x1275
88底舒宝对哈维氏弧菌的抑制效果缓释增氧,高效持久88通过吹气球
图片尺寸692x347
一株致病性海洋哈氏弧菌及其应用的制作方法
图片尺寸973x1000
谈"弧菌"色变,但是至今你还没有见过它长什么样子
图片尺寸1024x1024
令养殖户一直头疼的有害菌——弧菌,到底该如何搞定
图片尺寸640x594
资深养殖户不传之秘教你一招搞定弧菌病
图片尺寸331x220
哈维氏弧菌说明
图片尺寸500x500
弧菌是一种条件致病菌,在正常的养殖池塘中也是有弧菌存在的,也就是说
图片尺寸641x472
谈弧菌色变但是至今你还没有见过它长什么样子
图片尺寸504x797
让养殖户头疼的弧菌只要这样就能简单解决
图片尺寸588x670
弧菌形态介绍图
图片尺寸373x250
夏天高温肠炎白便爆发把弧菌赶尽杀绝才安心
图片尺寸1080x1440
池塘底部一些饲料,残饵和死藻上附着大量的副溶血弧菌,哈维氏弧菌
图片尺寸608x428
弧菌给我们养虾造成那么大的损失到底该如何处理弧菌
图片尺寸554x437